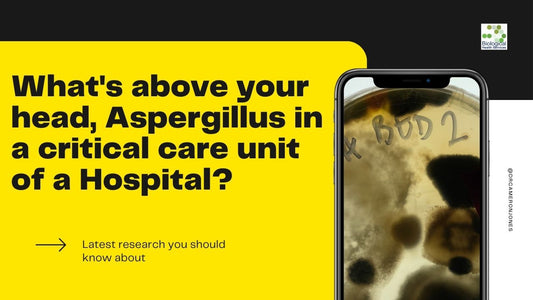

News

Revealed: The Unseen Enemy in UK Homes and Its ...
Mould in Residential Homes: The Hidden Danger and What You Can Do About It With an alarming number of homes suffering from mould and damp, it's crucial to understand the...
Revealed: The Unseen Enemy in UK Homes and Its ...
Mould in Residential Homes: The Hidden Danger and What You Can Do About It With an alarming number of homes suffering from mould and damp, it's crucial to understand the...

Shocking Hospital Secrets Exposed: Settle Plate...
Exposure to airborne microorganisms, viruses, and fungi in the built environment can have negative effects on human health. The settle plate method is a way to test air for microbial...
Shocking Hospital Secrets Exposed: Settle Plate...
Exposure to airborne microorganisms, viruses, and fungi in the built environment can have negative effects on human health. The settle plate method is a way to test air for microbial...

Checklist for Renters in Victoria: How to Deal ...
Introduction: As a renter in Victoria, it is essential that you are aware of your rights and responsibilities when it comes to the maintenance and repair of your rented property....
Checklist for Renters in Victoria: How to Deal ...
Introduction: As a renter in Victoria, it is essential that you are aware of your rights and responsibilities when it comes to the maintenance and repair of your rented property....

Understanding the Importance of Material Fact G...
Overview of the Material Fact Guidelines in Victorian Property Purchases: When it comes to purchasing property, whether it's land, buildings, or Strata in Victoria, there is an often overlooked legislation...
Understanding the Importance of Material Fact G...
Overview of the Material Fact Guidelines in Victorian Property Purchases: When it comes to purchasing property, whether it's land, buildings, or Strata in Victoria, there is an often overlooked legislation...
What's above your head, Aspergillus in a critic...
A recent paper highlighs once again the utility of the settle plate method. Using respiratory sample surveillance, three COVID-19 patients with Aspergillus were discovered in a newly opened general critical...
What's above your head, Aspergillus in a critic...
A recent paper highlighs once again the utility of the settle plate method. Using respiratory sample surveillance, three COVID-19 patients with Aspergillus were discovered in a newly opened general critical...

The Benefits of Tape Lifts for Mould Testing: A...
Introduction Mould can be a silent menace in our homes and offices, wreaking havoc on our health and the integrity of our buildings. Mould growth often goes unnoticed until it...
The Benefits of Tape Lifts for Mould Testing: A...
Introduction Mould can be a silent menace in our homes and offices, wreaking havoc on our health and the integrity of our buildings. Mould growth often goes unnoticed until it...